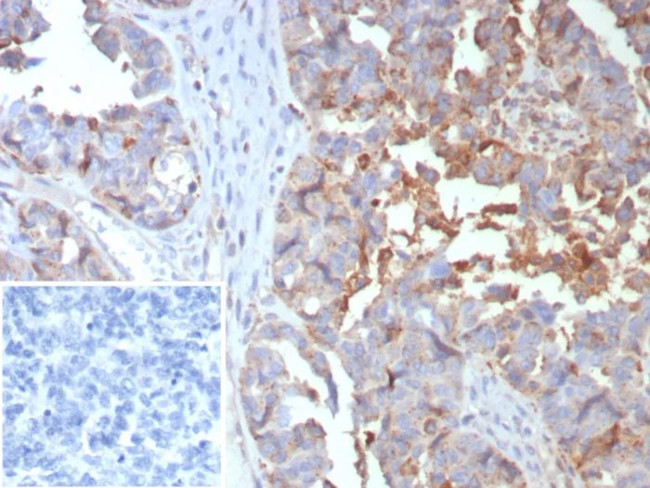
MX1/MX dynamin like GTPase 1 Antibody in Immunohistochemistry (Paraffin) (IHC (P))

Search
NeoBiotechnologies
MX1/MX dynamin like GTPase 1 Monoclonal Antibody (MX1/7529)
{{$productOrderCtrl.translations['antibody.pdp.commerceCard.promotion.promotions']}}
{{$productOrderCtrl.translations['antibody.pdp.commerceCard.promotion.viewpromo']}}
{{$productOrderCtrl.translations['antibody.pdp.commerceCard.promotion.promocode']}}: {{promo.promoCode}} {{promo.promoTitle}} {{promo.promoDescription}}. {{$productOrderCtrl.translations['antibody.pdp.commerceCard.promotion.learnmore']}}
产品信息
4599-MSM4-P1
种属反应
宿主/亚型
分类
类型
克隆号
抗原
偶联物
形式
浓度
规格
纯化类型
保存液
内含物
保存条件
运输条件
产品详细信息
Positive Control: breast cancer or colon cancer tissues. Human spleen Tonsil
Cellular Location: Cytoplasm.
靶标信息
This gene encodes a guanosine triphosphate (GTP)-metabolizing protein that participates in the cellular antiviral response. The encoded protein is induced by type I and type II interferons and antagonizes the replication process of several different RNA and DNA viruses. There is a related gene located adjacent to this gene on chromosome 21, and there are multiple pseudogenes located in a cluster on chromosome 4. Alternative splicing results in multiple transcript variants.
仅用于科研。不用于诊断过程。未经明确授权不得转售。
篇参考文献 (0)
生物信息学
蛋白别名: IFI-78K; Interferon-induced GTP-binding protein Mx1; Interferon-induced protein p78; interferon-inducible protein p78; Interferon-regulated resistance GTP-binding protein MxA; Myxoma resistance protein 1; myxovirus (influenza virus) resistance 1, interferon-inducible protein p78; Myxovirus resistance protein 1; p78 protein; unnamed protein product
基因别名: IFI-78K; IFI78; lncMX1-215; MX; MX1; MxA
UniProt ID: (Human) P20591
Entrez Gene ID: (Human) 4599